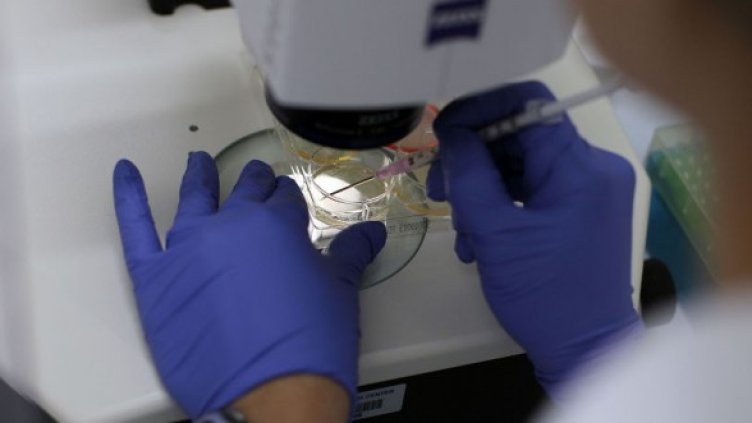
Снимка: Getty Images

Израелски изследователи оповестиха, че в лабораторна среда са успели да унищожат клетки, заразени с вируса на СПИН, без да засегнат здравите клетки, съобщи Франс прес.
Изследователите от Еврейския университет в Йерусалим поясниха, че са създали терапия на базата на пептиди, която води до самоунищожаване на заразените клетките.
Абрахам Лойтер обясни, че две седмици по-късно нямало следа от клетките, които са били мишена на новата терапия. Следователно може да се заключи, че те са били унищожени.
В статия, публикувана в сп. "AIDS Research and Therapy", израелският екип заяви, че тези изследвания могат да доведат до нова терапия срещу ХИВ.
Досегашните терапии срещу СПИН целяха да се унищожи вирусът в клетките, но бяха свързани с нов риск от инфекция, в случай че лечението е преустановено или вирусът е развил имунитет.
Това се случи Dnes, за важното през деня ни последвайте и в Google News Showcase.

От 1 юли влиза в сила фиксираното мито от 3 евро върху пратките от китайски е-търговци
От 1 юли влиза в сила фиксираното мито от 3 евро върху пратките от китайски е-търговци  Пазарът на бизнес имоти в Чехия е най-активният в Европа, чуждестранните инвеститори се връщат
Пазарът на бизнес имоти в Чехия е най-активният в Европа, чуждестранните инвеститори се връщат  Испания повишава прогнозата за икономическия растеж за 2026 г. въпреки войната в Иран
Испания повишава прогнозата за икономическия растеж за 2026 г. въпреки войната в Иран  Николина Митева: Електронните рецепти намалиха употребата на антибиотици у нас
Николина Митева: Електронните рецепти намалиха употребата на антибиотици у нас  „Супергърл“ не успя да надвие „Играта на играчките 5“ в боксофиса
„Супергърл“ не успя да надвие „Играта на играчките 5“ в боксофиса  Wall Street изоставя залозите за по-силно евро
Wall Street изоставя залозите за по-силно евро 
 Протест срещу Бюджет 2026: "Милионерите трябва да плащат, не работещите за 900 евро"
Протест срещу Бюджет 2026: "Милионерите трябва да плащат, не работещите за 900 евро"  Дрон от Израел уби трима души в Газа, сред жертвите е и дете
Дрон от Израел уби трима души в Газа, сред жертвите е и дете  Заплатите на военните са увеличени с 5%, в Бюджет 2026 са заложени повече пари
Заплатите на военните са увеличени с 5%, в Бюджет 2026 са заложени повече пари  Камионът с рисков товар е със скъсан заден мост и фалшива тахографска карта
Камионът с рисков товар е със скъсан заден мост и фалшива тахографска карта  Донев: Очакванията към Бюджет 2026 са нереалистични
Донев: Очакванията към Бюджет 2026 са нереалистични  Синдикати на протест: "Парите са в олигарсите, не в нас" (СНИМКИ)
Синдикати на протест: "Парите са в олигарсите, не в нас" (СНИМКИ) 
 ЦСКА ще почака: Кирил Десподов започна лагера с ПАОК
ЦСКА ще почака: Кирил Десподов започна лагера с ПАОК  Национал на България с трансфер в Славия
Национал на България с трансфер в Славия  Национал на България с тежка загуба в Италия
Национал на България с тежка загуба в Италия  Левски отново атакува голмайстор от Португалия, но цената му е сериозна
Левски отново атакува голмайстор от Португалия, но цената му е сериозна  Промениха правилата във Втора лига: Ясно е колко отбора ще изпадат през сезон 2026/27
Промениха правилата във Втора лига: Ясно е колко отбора ще изпадат през сезон 2026/27  Български футболен талант премина в Реал Мадрид
Български футболен талант премина в Реал Мадрид 
 Пълнолуние в Козирог на 30 юни: Какво да очаква всяка зодия
Пълнолуние в Козирог на 30 юни: Какво да очаква всяка зодия  Дневен хороскоп за 30 юни, вторник
Дневен хороскоп за 30 юни, вторник  20 закона на Мърфи за живота
20 закона на Мърфи за живота  Гръцка салата с паста – рецепта
Гръцка салата с паста – рецепта  ИГРА: Участвайте и можете да спечелите награди от филма „Миньони & чудовища“
ИГРА: Участвайте и можете да спечелите награди от филма „Миньони & чудовища“  Седмична нумерологична прогноза за 29 юни – 5 юли
Седмична нумерологична прогноза за 29 юни – 5 юли 
 продава, Двустаен апартамент, 61 m2 София, Надежда 1, 160000 EUR
продава, Двустаен апартамент, 61 m2 София, Надежда 1, 160000 EUR  продава, Офис, 62 m2 София, Медицинска академия, 320000 EUR
продава, Офис, 62 m2 София, Медицинска академия, 320000 EUR  продава, Офис, 62 m2 София, Център, 320000 EUR
продава, Офис, 62 m2 София, Център, 320000 EUR  продава, Двустаен апартамент, 62 m2 София, Медицинска академия, 320000 EUR
продава, Двустаен апартамент, 62 m2 София, Медицинска академия, 320000 EUR  продава, Къща, 171 m2 Габрово, Сарани, 82000 EUR
продава, Къща, 171 m2 Габрово, Сарани, 82000 EUR  продава, Тристаен апартамент, 61 m2 София, Център, 185000 EUR
продава, Тристаен апартамент, 61 m2 София, Център, 185000 EUR 
 Насрочиха разпоредителното заседание по възобновеното дело срещу кмета на Варна и още четирима общинари
Насрочиха разпоредителното заседание по възобновеното дело срещу кмета на Варна и още четирима общинари  След случая "Баба Алино": Мислят да криминализират незаконното строителство
След случая "Баба Алино": Мислят да криминализират незаконното строителство  Публикуваха резултатите от матурите след 7 и 10 клас
Публикуваха резултатите от матурите след 7 и 10 клас  Оборудваха Комплекса за социални услуги за деца и младежи във Варна със соларни панели
Оборудваха Комплекса за социални услуги за деца и младежи във Варна със соларни панели  Цената на петрола се стабилизира, след като САЩ и Иран отново се споразумяха
Цената на петрола се стабилизира, след като САЩ и Иран отново се споразумяха  Летовници спасиха делфинче на плаж във Варна (ВИДЕО)
Летовници спасиха делфинче на плаж във Варна (ВИДЕО) 
 НАСА разработва технология за презареждане в орбита за мисии в далечния космос
НАСА разработва технология за презареждане в орбита за мисии в далечния космос  Китайската космическа станция прелетя над Луната: Илюзия или реалност? (снимки)
Китайската космическа станция прелетя над Луната: Илюзия или реалност? (снимки)  AI подкопава доверието: Невронните мрежи се научиха да заблуждават експертите
AI подкопава доверието: Невронните мрежи се научиха да заблуждават експертите  Китай ще изстреля за първи път ракетата „Чанджън-10B“ през юли
Китай ще изстреля за първи път ракетата „Чанджън-10B“ през юли  Европейско-китайската мисия Smile достигна работна орбита
Европейско-китайската мисия Smile достигна работна орбита  Rocket Lab изстреля десетия сателит на Synspective
Rocket Lab изстреля десетия сателит на Synspective 












